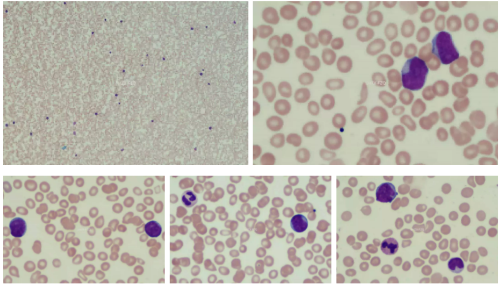
3.png

秦尤文、付兆強 | 上海市閘新中西醫結合醫院
轉載自:檢驗醫學
非特異性酯酶(NSE)有多種,根據反應所需的pH不同分為酸性,堿性及中性NSE,包括α-醋酸萘酚酯酶(α-NAE),醋酸AS-D萘酚酯酶(NAS-DAE)等。其染色結果及特點可以作為急性白血病的輔助診斷,在鑒別急性粒細胞白血病和急性單核細胞白血病時尤其有用。通常認為原始粒細胞α-NAE染色呈陰性或弱陽性,不被氟化鈉抑制,而原幼單核細胞多呈陽性或強陽性,可被氟化鈉抑制。而我們近日遇到的一例恰恰相反,讓我們來一看究竟。
男性,53歲,確診急性白血病9月余,因輕度貧血,血小板減低來診。
血常規:



盡管白細胞數正常,但白細胞散點圖明顯異常,需要涂片鏡檢。
生化:尿酸550umol/L↑,甘油三酯6.02mmol/L↑,乳酸脫氫酶2355 U/L↑,余無明顯異常。
外周血涂片:可見原始細胞
骨髓涂片:


可見大量異常細胞,比例及形態描述詳見后面的骨髓報告,一個突出的特點是原始細胞有核周淡染區。毫無疑問,該患者的白血病復發了。
細胞化學染色:

▲POX染色:原始細胞為陽性,多為4+,偶為3+,團塊狀,多位于近核凹陷處

▲CE染色:部分原始細胞陽性

▲PAS:部分原始細胞為彌漫狀陽性,多位于近核凹陷處

▲NAE染色:原始細胞為陽性

▲NAE+NaF:原始細胞為陰性;重做一遍,還是一樣的結果
這樣的結果令筆者困惑:本例的原始細胞POX均為陽性,且陽性程度不低,CE也是陽性,均支持粒系;但本例的原始細胞NAE為陽性,且陽性可被NaF完全抑制,這又支持單系。到底是啥?
各類檢查報告
骨髓細胞學:考慮為AML復發

免疫分型:并沒有單核系標志的表達。

染色體報告:復雜核型。

分子生物學報告:


AML1-ETO融合基因為陽性


存在KIT、CALR和DNMT3A突變。
綜上,患者的原發病應該是AML伴t(8;21)(q22;q22.1);RUNX1-RUNX1T1(舊稱AML1-ETO)。
初診時的報告(在其他醫院):

也是原始細胞的NAE陽性,可被NaF抑制。

![]()

因此,該單位考慮的是AML-M4。

初診時的免疫表型和現在稍有不同:初診時CD19為陽性,這次是陰性,不過CD56均為陽性,且初診時也沒有單核系標志的表達。
患者確診急性白血病9月,因輕度貧血、血小板減低來診,外周血即可見原始細胞70%,骨髓中原始細胞超過90%,按照療效標準,毫無疑問是復發了。
由于患者的原始細胞多見核周淡染區(魚肚白/朝陽紅),筆者考慮可能是伴t(8;21)(q22;q22.1);RUNX1-RUNX1T1(AML1-ETO)的AML。
回顧一下該類疾病的細胞形態特點:核質發育顯著不平衡,胞質呈橘黃色或偏堿性,含中性顆粒,常有空泡;此處引用重慶大學附屬腫瘤醫院血液腫瘤實驗室楊再林教授的經典語錄:黃沙厚土出朝陽!出現局部的魚肚白/朝陽紅表示分化不好,而出現彌漫的黃沙樣則表示分化較好。
細胞化學染色:POX陽性至強陽性,呈團塊狀;氯乙酸AS-D萘酚酯酶(CE,粒細胞酯酶)也呈強陽性,α-NAE和α-NBE呈陰性或弱陽性,前者的陽性結果不被NaF抑制。而本例患者的細胞化學染色出現了NAE陽性且被NaF抑制的不典型表現。
免疫分型:部分原始細胞高表達CD34,HLA-DR,MPO和CD13,弱表達CD33。通常有粒細胞分化的跡象,表現為部分細胞表達CD15和CD65。有時原始細胞群顯示成熟不同步的現象,如共表達CD34和CD15。常表達淋系標志如CD19和PAX5,還可表達胞質CD79a(我們遇到的這個病例在初診時確實有CD19表達)。某些病例TdT弱陽性。還有一部分病例表達CD56,常提示預后不良。
遺傳學:該病具有t(8;21)(q22;q22.1)易位和RUNX-RUNX1T1融合基因。核結合因子(CBF)是一個異二聚體,其兩個成分的基因——RUNX1(也稱AML1或CBFA)和CBFB的重排與急性白血病相關。t(8;21)(q22;q22.1)累及編碼核結合因子亞單位α的RUNX1基因和RUNX1T1(也稱ETO)基因。CBF轉錄因子是造血所必需的,而RUNX-RUNX1T1會使CBF發生異常轉化,導致造血異常,最終引起白血病。
診斷:WHO明確提到,診斷本病無需考慮原始細胞計數;換言之,當患者被證實有克隆性重現性細胞遺傳學異常t(8;21)(q22;q22.1)和/或RUNX1-RUNX1T1時,即使原始細胞<0.200,仍應診斷為AML。
預后:CD56的表達和KIT突變的存在提示預后較差(我們遇到的這個病例9個月就復發了,比較符合);伴有髓系肉瘤的患者的療效比那些沒有髓外病變的患者更差。
其實,急性早幼粒細胞白血病以外的急性髓系白血病有著同樣的治療方案;預后則更多的取決于細胞遺傳學與分子生物學的改變。因此很多時候,我們并不用過多糾結急性髓系白血病的原始細胞類型。MICM綜合診斷相比于單純形態學診斷的另一個優勢是,可通過細胞遺傳學和分子生物學的檢查結果對疾病的治療和預后判斷提供資料,單純的形態學在這方面有所欠缺。
不過,我們形態學工作者還是需要打破砂鍋問到底的精神,這樣才能不斷提高。雖然本例的原始細胞NAE為陽性,且可被NaF抑制,但其他特征均符合AML-M2b或AML伴t(8;21)(q22;q22.1);RUNX1-RUNX1T1,包括:有核周淡染區的原始細胞形態,POX的高陽性程度與酶型,CE的陽性,以及免疫分型檢測無單核系標記、CD19的表達等。
因此筆者認為,本例的原始細胞應該還是粒系的。由本例也能看出,在鑒別粒系/單核系原始細胞時,NAE染色+NaF抑制試驗并非100%特異,還是要結合其他檢查結果綜合分析。
參考文獻
[1]毛飛,許文榮. 臨床血液檢驗學[M]. 北京:科學出版社,2020.2
[2]白血病分類分型討論會關于急性非淋巴細胞白血病分型的修改建議[J]. 中華血液學雜志,1987,08(3):181
[3]沈悌,趙永強. 血液病診斷及療效標準. 第4版 . 北京:科學出版社,2018
[4]林澤嬉, 卞壽庚, 楊崇禮, 等. M2b白血病細胞的細胞化學染色特征. 中華血液學雜志,1992,13( 03 ): 138-140
[5]Swerdlow SH, Campo E, Harris NL, et al. (Eds): WHO Classification of Tumours of Haematopoietic and Lymphoid Tissues (Revised 4th edition). IARC: Lyon 2017
[6]中華醫學會血液學分會白血病淋巴瘤學組. 成人急性髓系白血病(非急性早幼粒細胞白血病)中國診療指南(2017年版) . 中華血液學雜志,2017,38( 3 ): 177-182.
[7]NCCN Clinical Practice Guidelines in Oncology (NCCN Guidelines?),Acute Myeloid Leukemia,Version 4.2020
[8]Kenneth Kaushansky,Marshall A. Lichtman,Josef T. Prchal,etal. Williams Hematology. Ninth Edition. USA:McGraw-Hill Education,2016
[9]急性白血病療效標準(全國白血病化學治療討論會1987.11.20于蘇州)[J]. 中華血液學雜志,1988,09(3):183-184.